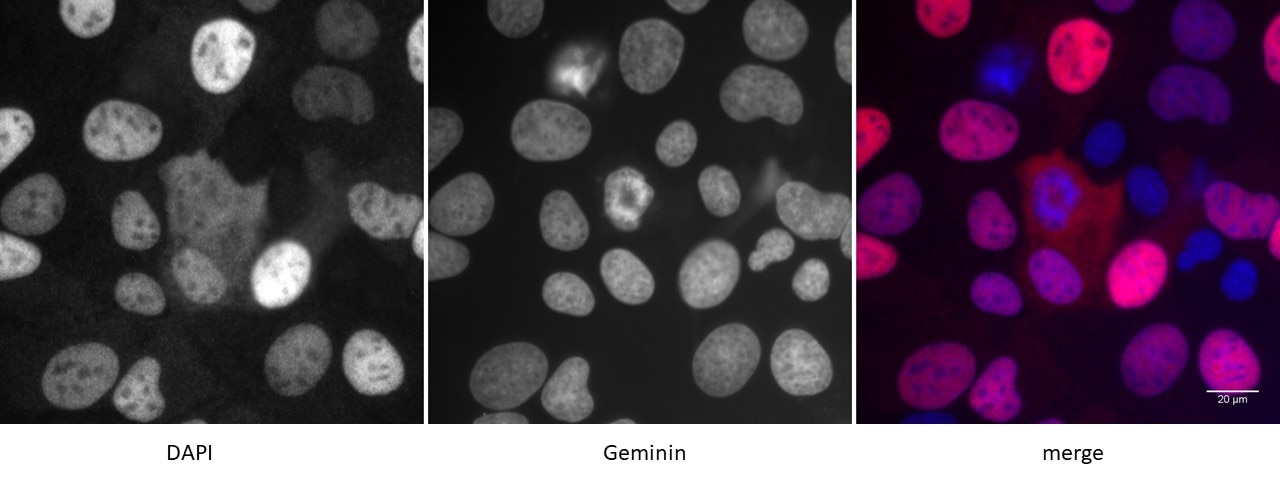
Detection of Geminin by immunofluorescence U2OS cells were stained with Geminin antibody at a dilution of 1:500. Left panel: DAPI. Middle panel: Geminin antibody staining. Right panel: merge.

Geminin antibody (pAb)
Host / Isotype
Rabbit / Serum
Reactivity
Human
Applications
IF, IP, WB
Cat No : 61135,61136 61135
Synonyms
Validation Data Gallery
Product Information
| Tested Applications |
IF, IP, WB
Applications Validated by Active Motif: IF: 1:500 dilution |
| Tested Reactivity | Human |
| Host / Isotype | Rabbit / Serum |
| Class | Polyclonal |
| Type | Antibody |
| Immunogen | This Geminin antibody was raised against full-length recombinant human Geminin protein. |
| Full Name | Geminin antibody (pAb) |
| Synonyms | Geminin, Gemi, GMNN, centrosome, DNA replication, MCM complex, CDT1, licensing, embryonic stem cell, esc, pluripotency, pluripotent, cell cycle, sample |
| Molecular weight | 33 kDa |
| GenBank accession number | NP_056979 |
| RRID | AB_2793521 |
| Purification Method | None |
| Buffer | Rabbit serum containing 30% glycerol and 0.035% sodium azide. Sodium azide is highly toxic. |
| Storage | Some products may be shipped at room temperature. This will not affect their stability or performance. Avoid repeated freeze/thaw cycles by aliquoting items into single-use fractions for storage at -20°C for up to 2 years. Keep all reagents on ice when not in storage. |
Background Information
Geminin is a crucial cell cycle regulatory protein that controls DNA replication and centrosome function. Geminin inhibits DNA replication by preventing the binding of the MCM complex into the pre-replication complex. Geminin accumulates during S, G2, and M phases, and disappears at the time of the metaphase-anaphase transition. Geminin functions as a homotetramer and interacts with DNA replication licensing factor CDT1. The interaction between Geminin and CDT1 is crucial to restrict DNA replication to once per cell cycle. Geminin is required for the formation of pluripotent cells in the developing embryo and essential for pluripotency in the embryonic stem cells. In ESCs, Geminin remains during G1 and sustains core pluripotency factors (Oct4, Sox2, and Nanog) by antagonizing the action of the chromatin remodeling protein BRG1.